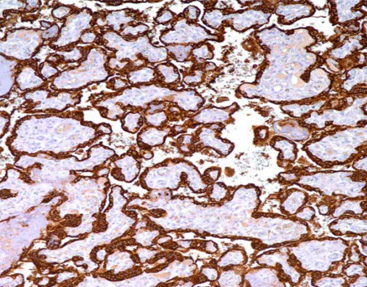

PRODUCT CATEGORY
PRODUCT CATEGORY
CONTACT US
Phone
Email
Address
6 Cuizhu St, Zhong Yuan Qu, Zheng Zhou Shi, He Nan Sheng, China, 450001
HPL (polyclonal), RPab
HPL (Human Placental Lactogen )is a peptide hormone synthesized by placental nourishing layer cells that can determine ectopic and intrauterine pregnancy in pregnancy products. It is mainly used for the diagnosis and differential diagnosis of nourishing layer cell tumors. It is of some significance in the differential diagnosis of complete and incompletehydatidiformmole(HPL+) and velvet cancer (HPL-).
Staining Tissue
[As Figure shows]
Choriocarcinoma tissue stained with HPL
[Intended Use]
HPL (Human Placental Lactogen )is a peptide hormone synthesized by placental nourishing layer cells that can determine ectopic and intrauterine pregnancy in pregnancy products. It is mainly used for the diagnosis and differential diagnosis of nourishing layer cell tumors. It is of some significance in the differential diagnosis of complete and incompletehydatidiformmole(HPL+) and velvet cancer (HPL-).
[Specifications]
| Product Name | HPL (polyclonal), RPab |
| Catalog No. | CHR-0250 |
| Intended Use | IVD, RUO |
| Species Reactivity | Human; others not tested |
| Cellular Localization | Cytoplasm / Nucleus |
| Antibody Type | Rabbit Monoclonal |
| Clone | Polyclonal |
| Format and Volume | Ready-to-use: 1mL, 3mL, 6mL Concentrated: 0.1mL, 0.2mL and 1mL |
[Datasheets & SDS]
| IVD Datasheet (IFU) | ↕️ Download |
| RUO Datasheet (IFU) | ↕️ Download |
| SDS sheet | check with sales |
[Storage and Validity]
Store at 2~8°C. Avoid freezing.
Maintain temperature below room temperature during transport, ensuring it does not exceed one week.